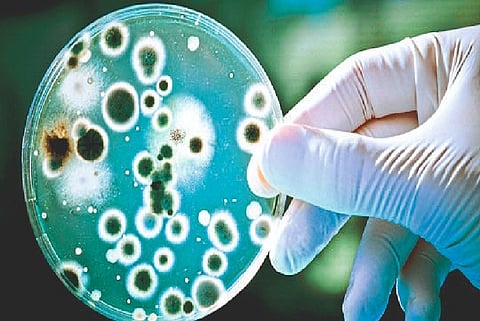
one patient infected with Brucellosis bacterial infection in nagpur

नागपूर : सात महिने कोरोना विषाणूने धुमाकूळ घातल्यानंतर आता एक जिवाणू दबक्या पावलाने हल्ला करायला सज्ज झाला आहे. चीनमध्ये अनेकांना या जिवाणूने आपल्या विळख्यात घेतले आहे. भारतातही काही ठिकाणी या आजाराचे लक्षणे दिसून आली आहेत. नागपुरातही एका व्यक्तीला लागण झाल्याची माहिती आहे. या जिवाणूचे नाव ब्रुसेल्ला असून यामुळे ब्रूसेलोसिस या संसर्गजन्य रोगाचा प्रादुर्भाव होत आहे.
ब्रुसेलोसिस हा एक संसर्गजन्य रोग आहे. जेव्हा लोक संसर्गित प्राणी, दूषित उत्पादनांशी संपर्क साधतात तेव्हा त्यांना हा आजार होऊ शकतो. सामान्यतः संसर्ग झालेल्या प्राण्यांमध्ये मेंढ्या, गुरे, शेळ्या, डुक्कर आणि कुत्री यांचा समावेश आहे. ब्रुसेलोसिसचा प्रसार मानवांमध्ये होणे दुर्मीळ असल्याचे जाणकारांचे मत आहे. संक्रमित जनावरांच्या संपर्कात आल्यास मानवालाही याचा प्रादुर्भाव होतो. तसेच संक्रमित जनावरांचे पाश्चरीकरण न केलेले दूध व पनीरपासूनसुध्दा फैलाव होण्याची शक्यता असते.
जिवाणूंसह काम करणाऱ्या प्रयोगशाळांमधील लोकांना हा धोका जास्त असतो. कत्तलखाने आणि मांस-पॅकिंग कर्मचाऱ्यांदेखील जिवाणूचा धोका असतो. शेळ्या, मेंढ्या, गाई किंवा उंटांना संसर्ग झाल्यास त्यांचे दूध जिवाणूने दूषित होते. जर संक्रमित जनावराचे दूध पाश्चराइझ केले नाही तर हे संक्रमण दूध किंवा चीज सेवन करणाऱ्यांना होऊ शकते. ब्रूसेलोसिस रोगापासून बचाव करण्यासाठी उपलब्ध असलेली लस तज्ज्ञ पशुवैद्यकामार्फत जनावरांना टोचून घ्यावी, असे पशुवैद्यकांचे म्हणणे आहे.
चीनमध्ये असा झाला फैलाव -
चिनमधील लानझोऊ येथे पशुवैद्यकीय संशोधन संस्था आहे. येथे ब्रूसेलोसिस विरोधी लस तयार केली जाते. मागील वर्षी या परिसरातील एका फॅक्टरीमधून या जिवाणूचा फैलाव झाल्याची माहिती आहे. या लसीमध्ये एक्सपायर (कालबाह्य) झालेले कीटाणुनाशक (डिसइन्फेक्टन्ट) वापरण्यात आले होते. हवेद्वारे हे जिवाणू सभोवताली पसरले आणि अनेकांना प्रादुर्भाव झाला असल्याचे जाणकार सांगतात.
उपचार उपलब्ध -
एखाद्या संक्रमित जनावराचे रक्त, द्रव किंवा ऊती यासोबत आपले डोळे, नाक, तोंड किंवा त्वचेच्या संपर्कात आला तर आपण ब्रुसेलोसिसने आजारी पडू शकतो. ब्रुसेलोसिसचा जिवाणू संक्रमित प्राण्यांच्या संपर्काद्वारे प्रवेश करू शकतो. तसेच याचा संसर्ग श्वासोच्छ्वासाने देखील होऊ शकतो. जिवाणू त्वचेच्या जखमा किंवा त्वचेद्वारे शरीरात प्रवेश करतात. मानवांमध्ये खूप मोठ्या प्रमाणात हा आजार आढळत नसून या आजारावर उपचार आहेत. या आजाराची लक्षणे तपासून उपचार करावेत, असे नागपूर पशुवैद्यकीय महाविद्यालयातील पशुप्रजननशास्त्र विभागातील साहाय्यक प्राध्यापक डॉ. एम. एस. बावस्कर यांनी सांगितले.
आजाराची लक्षणे :
सकाळ+ चे सदस्य व्हा
ब्रेक घ्या, डोकं चालवा, कोडे सोडवा!
शॉपिंगसाठी 'सकाळ प्राईम डील्स'च्या भन्नाट ऑफर्स पाहण्यासाठी क्लिक करा.
Read latest Marathi news, Watch Live Streaming on Esakal and Maharashtra News. Breaking news from India, Pune, Mumbai. Get the Politics, Entertainment, Sports, Lifestyle, Jobs, and Education updates, मराठी ताज्या बातम्या, मराठी ब्रेकिंग न्यूज, मराठी ताज्या घडामोडी. And Live taja batmya on Esakal Mobile App. Download the Esakal Marathi news Channel app for Android and IOS.